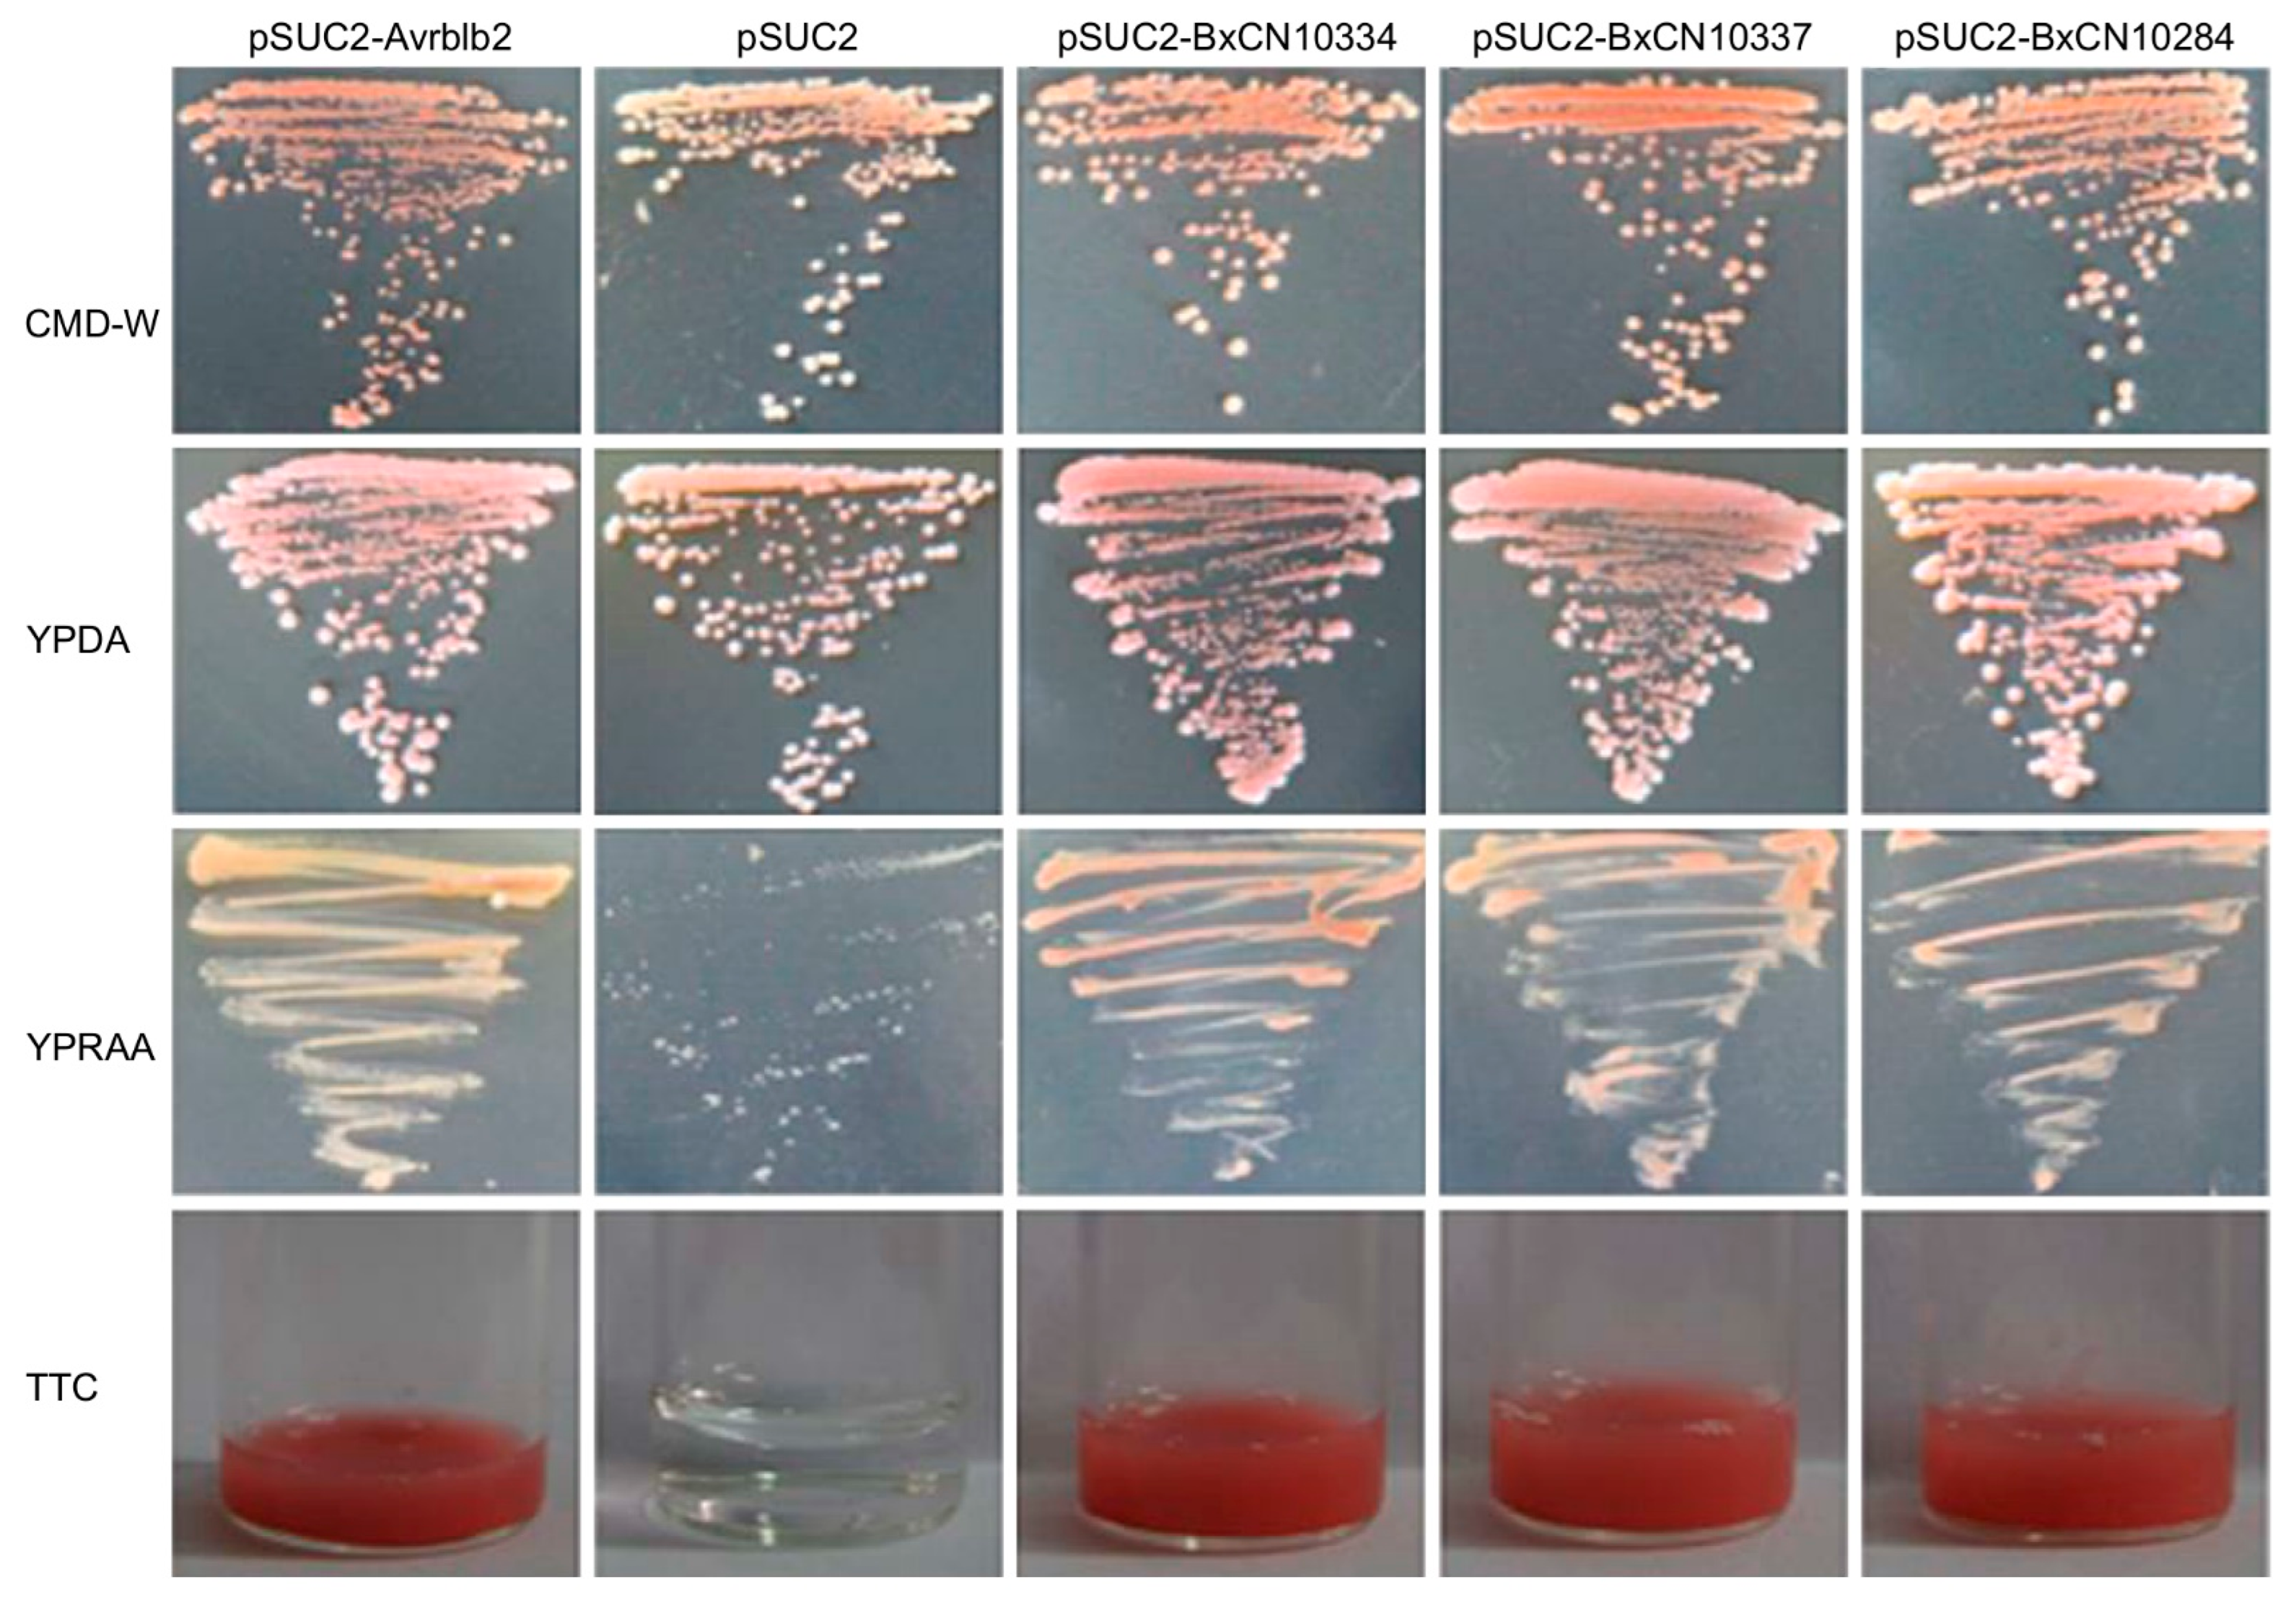
Ijms 23 10437 g006

Roles of Species-Specific Legumains in Pathogenicity of the Pinewood Nematode Bursaphelenchus xylophilus
Abstract
1. Introduction
2. Results
2.1. Diversity of Peptidases in Plant-Parasitic Nematodes by Comparative Genome Analysis
2.2. Expansion of Cysteine Peptidase in Family C13 in B. xylophilus and Their Evolutionary Relationship
2.3. Expression Patterns of B. xylophilus-Specific Legumain Genes during the Nematode Infection in Pine Host
2.4. Functional Complementation of γVPE-Deficient Arabidopsis by Expression of B. xylophilus-Specific Legumains in Mediating Plant Cell Death
2.5. Validation of Secretory Activities of B. xylophilus-Specific Legumains
2.6. Identification of Genes Involved in Nematode Legumain-Mediated FB1-Induced Plant Cell Death
3. Discussion
4. Experimental Procedures
4.1. Nematode Strains
4.2. Plant Materials
4.3. Genome Sequencing and Assembly
4.4. Protein-Coding Gene Annotation
4.5. Phylogenetic Tree Construction and Evolutionary Analysis
4.6. RNA Isolation, RT-PCR and Quantitative Real-Time PCR
4.7. Functional Complementation Assay
4.8. In Situ Hybridization
4.9. Secretory Activity Assay
4.10. RNA Sequencing and DEG Identification
Supplementary Materials
Author Contributions
Funding
Institutional Review Board Statement
Informed Consent Statement
Data Availability Statement
Acknowledgments
Conflicts of Interest
References
- Atkinson, H.J.; Babbitt, P.C.; Sajid, M. The global cysteine peptidase landscape in parasites. Trends Parasitol. 2009, 25, 573–581. [Google Scholar] [CrossRef] [PubMed]
- Barrett, A.J.; Chen, J.-M. Chapter 518-Animal legumain. In Handbook of Proteolytic Enzymes; Rawlings, N.D., Salvesen, G., Eds.; Elsevier: Tokyo, Japan, 2013; Volume 2, pp. 2309–2314. [Google Scholar]
- Rawlings, N.D.; Barrett, A.J.; Thomas, P.D.; Huang, X.; Bateman, A.; Finn, R.D. The MEROPS database of proteolytic enzymes, their substrates and inhibitors in 2017 and a comparison with peptidases in the PANTHER database. Nucleic Acids Res. 2018, 46, D624–D632. [Google Scholar] [CrossRef]
- Hara-Nishimura, I.; Hatsugai, N.; Nakaune, S.; Kuroyanagi, M. Vacuolar processing enzyme: An executor of plant cell death. Curr. Opin. Plant Biol. 2005, 8, 404–408. [Google Scholar] [CrossRef]
- Kuroyanagi, M.; Yamada, K.; Hatsugai, N.; Kondo, M.; Nishimura, M.; Hara-Nishimura, I. Vacuolar processing enzyme is essential for mycotoxin-induced cell death in Arabidopsis thaliana. J. Biol. Chem. 2005, 280, 32914–32920. [Google Scholar] [CrossRef]
- Hatsugai, N.; Yamada, K.; Goto-Yamada, S.; Hara-Nishimura, I. Vacuolar processing enzyme in plant programmed cell death. Front. Plant Sci. 2015, 6, 234. [Google Scholar] [CrossRef]
- Hatsugai, N.; Kuroyanagi, M.; Yamada, K.; Meshi, T.; Tsuda, S.; Kondo, M.; Nishimura, M.; Hara-Nishimura, I. A plant vacuolar peptidase, VPE, mediates virus-induced hypersensitive cell death. Science 2004, 305, 855–858. [Google Scholar] [CrossRef] [PubMed]
- Dall, E.; Brandstetter, H. Structure and function of legumain in health and disease. Biochimie 2016, 22, 126–150. [Google Scholar] [CrossRef] [PubMed]
- Wu, B.; Yin, J.; Texier, C.; Roussel, M.; Tan, K.S.W. Blastocystis legumain is localized on the cell surface, and specific inhibition of its activity implicates a pro-survival role for the enzyme. J. Biol. Chem. 2010, 285, 1790–1798. [Google Scholar] [CrossRef]
- Götz, B.; Klinkert, M.Q. Expression and partial characterization of a cathepsin B-like enzyme (Sm31) and a proposed ‘haemoglobinase’ (Sm32) from Schistosoma mansoni. Biochem. J. 1993, 290 Pt 3, 801–806. [Google Scholar] [CrossRef][Green Version]
- Dalton, J.P.; Brindley, P.J. Schistosome asparaginyl endopeptidase SM32 in hemoglobin digestion. Parasitol. Today 1996, 12, 125. [Google Scholar] [CrossRef]
- Ju, J.-W.; Joo, H.-N.; Lee, M.-R.; Cho, S.-H.; Cheun, H.-I.I.; Kim, J.-Y.; Lee, Y.-H.; Lee, K.-J.; Sohn, W.-M.; Kim, D.-M.; et al. Identification of a serodiagnostic antigen, legumain, by immunoproteomic analysis of excretory-secretory products of Clonorchis sinensis adult worms. Proteomics 2009, 9, 3066–3078. [Google Scholar] [CrossRef] [PubMed]
- Mota, M.M.; Vieira, P. Pine Wilt Disease: A Worldwide Threat to Forest Ecosystems; Springer Science+Business Media: New York, NY, USA, 2008. [Google Scholar]
- Kobayashi, F.; Yamave, A.; Ikeda, T. The Japanese pine sawyer beetle as the vector of pine wilt. Ann. Rev. Ent. 1984, 29, 115–135. [Google Scholar] [CrossRef]
- Futai, K. Pine wood nematode, Bursaphelenchus xylophilus. Annu. Rev. Phytopathol. 2013, 51, 61–83. [Google Scholar] [CrossRef] [PubMed]
- Mamiya, Y. Inoculation of the first year pine (Pinus densiflora) seedlings with Bursaphelenchus lignicolus and the histopathology of diseased seedlings. J. Jpn. For. Soc. 1980, 62, 176–183. [Google Scholar]
- Mamiya, Y. Histopathological observations of Bursaphelenchus xylophilus in symptomatic tissues of pinewood. In Pine Wilt Disease: A Worldwide Threat to Forest Ecosystems; Mota, M.M., Vieira, P., Eds.; Springer Science+Business Media: New York, NY, USA, 2008; pp. 321–334. [Google Scholar]
- Kusunoki, M. Symptom developments of pine wilt disease-histological observations with electron microscope. Ann. Phytopathol. Soc. Jpn. 1987, 53, 622–629. [Google Scholar] [CrossRef][Green Version]
- Nobuchi, T.; Tominaga, T.; Futai, K.; Harada, H. Cytological study of pathological changes in Japanese black pine (Pinus thunbergii) seedlings after inoculation with pine-wood nematode (Bursaphelenchus xylophilus). Bull. Kyoto Univ. For. 1984, 56, 224–233. [Google Scholar]
- Hara, N.; Takeuchi, Y.; Futai, K. Cytological changes in ray parenchyma cells of seedlings of three pine species infected with the pine wilt disease. Jpn. J. Nematol. 2006, 36, 23–32. [Google Scholar] [CrossRef][Green Version]
- Zhao, B.G.; Futai, K.; Sutherland, J.R.; Takeuch, Y. Pine Wilt Disease; Springer: Kato Bunmeisha, Japan, 2008. [Google Scholar]
- Kikuchi, T.; Cotton, J.A.; Dalzell, J.J.; Hasegawa, K.; Kanzaki, N.; McVeigh, P.; Takanashi, T.; Tsai, I.J.; Assefa, S.A.; Cock, P.J.A.; et al. Genomic insights into the origin of parasitism in the emerging plant pathogen Bursaphelenchus xylophilus. PLoS Pathog. 2011, 7, e1002219. [Google Scholar] [CrossRef]
- Shinya, R.; Takeuchi, Y.; Miura, N.; Kuroda, K.; Ueda, M.; Futai, K. Surface coat proteins of the pine wood nematode, Bursaphelenchus xylophilus: Profiles of stage-and isolate-specific characters. Nematology 2009, 11, 429–438. [Google Scholar]
- Shinya, R.; Morisaka, H.; Kikuchi, T.; Takeuchi, Y.; Ueda, M.; Futai, K. Secretome analysis of the pine wood nematode reveals the tangled roots of parasitism and its potential for molecular mimicry. PLoS ONE 2013, 8, e67377. [Google Scholar] [CrossRef]
- Espada, M.; Silva, A.C.; van den Akker, S.E.; Cock, P.J.A.; Mota, M.; Jones, J.T. Identification and characterization of parasitism genes from the pinewood nematode Bursaphelenchus xylophilus reveals a multilayered detoxification strategy. Mol. Plant Pathol. 2016, 17, 286–295. [Google Scholar] [CrossRef] [PubMed]
- Hu, L.-J.; Wu, X.-Q.; Ding, X.-L.; Ye, J.-R. Comparative transcriptomic analysis of candidate effectors to explore the infection and survival strategy of Bursaphelenchus xylophilus during different interaction stages with pine trees. BMC Plant Biol. 2021, 21, 224. [Google Scholar] [CrossRef] [PubMed]
- Hatsugai, N.; Hara-Nishimura, I. Two vacuole-mediated defense strategies in plants. Plant Signal. Behav. 2010, 5, 1568–1570. [Google Scholar] [CrossRef]
- Devarenne, T.P.; Martin, G.B. Manipulation of plant programmed cell death pathways during plant-pathogen interactions. Plant Signal. Behav. 2007, 2, 188–198. [Google Scholar] [CrossRef][Green Version]
- Hofius, D.; Li, L.; Hafren, A.; Coll, N.S. Autophagy as an emerging arena for plant-pathogen. Curr. Opin. Plant Biol. 2017, 38, 117–123. [Google Scholar] [CrossRef]
- Mukhtar, M.S.; McCormack, M.E.; Argueso, C.T.; Pajerowska-Mukhtar, K.M. Pathogen tactics to manipulate plant cell death. Curr. Biol. 2016, 26, R608–R619. [Google Scholar] [CrossRef] [PubMed]
- Leary, A.Y.; Sanguankiattichai, N.; Duggan, C.; Tumtas, Y.; Pandey, P.; E Segretin, M.; Linares, J.S.; Savage, Z.D.; Yow, R.J.; O Bozkurt, T. Modulation of plant autophagy during pathogen attack. J. Exp. Bot. 2018, 69, 1325–1333. [Google Scholar] [CrossRef]
- Misas-Villamil, J.C.; Toenges, G.; Kolodziejek, I.; Sadaghiani, A.M.; Kaschani, F.; Colby, T.; Bogyo, M.; van der Hoorn, R.A. Activity profiling of vacuolar processing enzymes reveals a role for VPE during oomycete infection. Plant J. 2013, 73, 689–700. [Google Scholar] [CrossRef]
- Dickman, M.B.; de Figueiredo, P. Death be not proud—Cell death control in plant fungal interactions. PLoS Pathog. 2013, 9, e1003542. [Google Scholar] [CrossRef][Green Version]
- Van Doorn, W.G.; Beers, E.P.; Dangl, J.L.; Franklin-Tong, V.E.; Gallois, P.; Hara-Nishimura, H.; Jones, A.M.; Kawai-Yamada, M.; Lam, E.; Mundy, J.; et al. Morphological classification of plant cell deaths. Cell Death Differ. 2011, 18, 1241–1246. [Google Scholar] [CrossRef]
- Jones, J.T.; Moens, M.; Mota, M.; Li, H.; Kikuchi, T. Bursaphelenchus xylophilus: Opportunities in comparative genomics and molecular host–parasite interactions. Mol. Plant Pathol. 2008, 9, 357–368. [Google Scholar] [CrossRef] [PubMed]
- Somvanshi, V.S.; Tathode, M.; Shukla, R.N.; Rao, U. Nematode genome announcement: A draft genome for rice root-knot nematode, Meloidogyne graminicola. J. Nematol. 2018, 50, 111–116. [Google Scholar] [CrossRef] [PubMed]
- Ganji, S.; Sanders, W.S.; Stokes, J.V.; Showmaker, K.; Bartlett, B.; Wang, H.; Wubben, M.; McCarthy, F.; Magbanua, Z.; Peterson, D. The genome of reniform nematode, Rotylenchulus reniformis. In Proceedings of the 10th Conference of the Midsouth Computational Biology and Bioinformatics Society, Columbia, SC, USA, 5–6 April 2013; p. 102. [Google Scholar]
- Showmaker, K.C.; Sanders, W.S.; Akker, S.E.A.; Martin, B.E.; Platt, R.N., II; Stokes, J.V.; Hsu, C.-H.; Bartlett, B.D.; Peterson, D.G.; Wubben, M.J. A genomic resource for the sedentary semi-endoparasitic reniform nematode, Rotylenchulus reniformis Linford & Oliveira. J. Nematol. 2019, 51, e2019-13. [Google Scholar]
- Szitenberg, A.; Jaramillo, L.S.; Blok, V.C.; Laetsch, D.R.; Joseph, S.; Williamson, V.M.; Blaxter, M.L.; Lunt, D.H. Comparative genomics of apomictic root-knot nematodes: Hybridization, ploidy, and dynamic genome change. Genome Biololgy Evol. 2017, 9, 2844–2861. [Google Scholar] [CrossRef] [PubMed]
- Petersen, T.N.; Brunak, S.; Von Heijne, G.; Nielsen, H. SignalP 4.0: Discriminating signal peptides from transmembrane regions. Nat. Methods 2011, 8, 785–786. [Google Scholar] [CrossRef]
- Baek, M.; DiMaio, F.; Anishchenko, I.; Dauparas, J.; Ovchinnikov, S.; Lee, G.R.; Wang, J.; Cong, Q.; Kinch, L.N.; Schaeffer, R.D.; et al. Accurate prediction of protein structures and interactions using a three-track neural network. Science 2021, 373, 871–876. [Google Scholar] [CrossRef]
- Zhang, Y.; Skolnick, J. TM-align: A protein structure alignment algorithm based on TM-score. Nucleic Acids Res. 2005, 33, 2302–2309. [Google Scholar] [CrossRef]
- Wilson, C.A.; Kreychman, J.; Gerstein, M. Assessing annotation transfer for genomics: Quantifying the relations between protein sequence, structure and function through traditional and probabilistic scores. J. Mol. Biol. 2000, 297, 233–249. [Google Scholar] [CrossRef]
- Alberts, B.; Johnson, A.; Lewis, J.; Raff, M.; Roberts, K.; Walter, P. Analyzing protein structure and function. In Molecular Biology of the Cell, 4th ed.; Garland Science: New York, NY, USA, 2002. Available online: https://www.ncbi.nlm.nih.gov/books/NBK26820/ (accessed on 29 December 2019).
- Kusumoto, D.; Yonemichi, T.; Inoue, H.; Hirao, T.; Watanabe, A.; Yamada, T. Comparison of histological responses and tissue damage expansion between resistant and susceptible Pinus thunbergii infected with pine wood nematode Bursaphelenchus xylophilus. J. For. Res. 2014, 19, 285–294. [Google Scholar] [CrossRef]
- Williams, B.; Dickman, M. Plant programmed cell death: Can’t live with it; can’t live without it. Mol. Plant Pathol. 2008, 9, 531–544. [Google Scholar] [CrossRef]
- Webster, J.M.; Anderson, R.V.; Baillie, D.L.; Beckenbach, K.; Curran, J.; Rutherford, T.A. DNA probes for differentiating isolates of the pinewood nematode species complex. Rev. Nematol. 1990, 13, 255–263. [Google Scholar]
- Bolla, R.I.; Boschert, M. Pinewood nematode species complex: Interbreeding potential and chromosome number. J. Nematol. 1993, 25, 227–238. [Google Scholar] [PubMed]
- Wingfield, M.J.; Blanchme, R.A.; Kondo, E. Comparison of the pine wood nematode, Bursaphelenchus xylophilus from pine and balsam fir. Eur. J. Plant Pathol. 1983, 13, 360–372. [Google Scholar] [CrossRef]
- Kiyohara, T.; Bolla, R.I. Pathogenic variability among populations of the pinewood nematode, Bursaphelenchus xylophilus. For. Sci. 1990, 36, 1061–1076. [Google Scholar]
- Li, R.; Fan, W.; Tian, G.; Zhu, H.; He, L.; Cai, J.; Huang, Q.; Cai, Q.; Li, B.; Bai, Y.; et al. The sequence and de novo assembly of the giant panda genome. Nature 2010, 463, 311–317. [Google Scholar] [CrossRef] [PubMed]
- Chu, J.S.; Baillie, D.L.; Chen, N. Convergent evolution of RFX transcription factors and ciliary genes predated the origin of metazoans. BMC Ecol. Evol. 2010, 10, 130. [Google Scholar] [CrossRef] [PubMed]
- Angiuoli, S.V.; Salzberg, S.L. Mugsy: Fast multiple alignment of closely related whole genomes. Bioinformatics 2011, 27, 334–342. [Google Scholar] [CrossRef]
- Parra, G.; Bradnam, K.; Korf, I. CEGMA: A pipeline to accurately annotate core genes in eukaryotic genomes. Bioinformatics 2007, 23, 1061–1067. [Google Scholar] [CrossRef]
- Price, A.L.; Jones, N.C.; Pevzner, P.A. De novo identification of repeat families in large genomes. Bioinformatics 2005, 21, 1351–1358. [Google Scholar] [CrossRef]
- Bao, Z.; Eddy, S.R. Automated de novo identification of repeat sequence families in sequenced genomes. Genome Res. 2002, 12, 1269–1276. [Google Scholar] [CrossRef]
- She, R.; Chu, J.S.; Uyar, B.; Wang, J.; Wang, K.; Chen, N. genBlastG: Using BLAST searches to build homologous gene models. Bioinformatics 2011, 27, 2141–2143. [Google Scholar] [CrossRef] [PubMed]
- Langmead, B.; Salzberg, S.L. Fast gapped-read alignment with Bowtie 2. Nat. Methods 2012, 9, 357–359. [Google Scholar] [CrossRef] [PubMed]
- Pollier, J.; Rombauts, S.; Goossens, A. Analysis of RNA-Seq data with TopHat and Cufflinks for genome-wide expression analysis of jasmonate-treated plants and plant cultures. Methods Mol. Biol. 2013, 1011, 305–315. [Google Scholar] [PubMed]
- Finn, R.D.; Coggill, P.; Eberhardt, R.Y.; Eddy, S.R.; Mistry, J.; Mitchell, A.L.; Potter, S.C.; Punta, M.; Qureshi, M.; Sangrador-Vegas, A.; et al. The Pfam protein families database: Towards a more sustainable future. Nucleic Acids Res. 2016, 44, D279–D285. [Google Scholar] [CrossRef]
- Lu, S.; Wang, J.; Chitsaz, F.; Derbyshire, M.K.; Geer, R.C.; Gonzales, N.R.; Gwadz, M.; Hurwitz, D.I.; Marchler, G.H.; Song, J.S.; et al. CDD/SPARCLE: The conserved domain database in 2020. Nucleic Acids Res. 2020, 48, D265–D268. [Google Scholar] [CrossRef]
- Emanuelsson, O.; Nielsen, H.; Brunak, S.; Von Heijne, G. Predicting subcellular localization of proteins based on their N-terminal amino acid sequence. J. Mol. Biol. 2000, 300, 1005–1016. [Google Scholar] [CrossRef]
- Krogh, A.; Larsson, B.; Von Heijne, G.; Sonnhammer, E.L. Predicting transmembrane protein topology with a hidden Markov model: Application to complete genomes. J. Mol. Biol. 2001, 305, 567–580. [Google Scholar] [CrossRef]
- Chen, C.; Chen, H.; Zhang, Y.; Thomas, H.R.; Frank, M.H.; He, Y.; Xia, R. TBtools: An integrative toolkit developed for interactive analyses of big biological data. Mol. Plant 2020, 13, 1194–1202. [Google Scholar] [CrossRef]
- Wang, J.; Youkharibache, P.; Zhang, D.; Lanczycki, C.J.; Geer, R.C.; Madej, T.; Phan, L.; Ward, M.; Lu, S.; Marchler, G.H.; et al. iCn3D, a web-based 3D viewer for sharing 1D/2D/3D representations of biomolecular structures. Bioinformatics 2020, 36, 131–135. [Google Scholar] [CrossRef]
- Stanke, M.; Keller, O.; Gunduz, I.; Hayes, A.; Waack, S.; Morgenstern, B. AUGUSTUS: Ab initio prediction of alternative transcripts. Nucleic Acids Res. 2006, 34, 435–439. [Google Scholar] [CrossRef]
- Edgar, R.C. MUSCLE: Multiple sequence alignment with high accuracy and high throughput. Nucleic Acids Res. 2004, 32, 1792–1797. [Google Scholar] [CrossRef]
- Darriba, D.; Taboada, G.L.; Doallo, R.; Posada, D. ProtTest 3: Fast selection of best-fit models of protein evolution. Bioinformatics 2011, 27, 1164–1165. [Google Scholar] [CrossRef] [PubMed]
- Tamura, K.; Stecher, G.; Peterson, D.; Filipski, A.; Kumar, S. MEGA6: Molecular evolutionary genetics analysis version 6.0. Mol. Biol. Evol. 2013, 30, 2725–2729. [Google Scholar] [CrossRef] [PubMed]
- Clough, S.J.; Bent, A.F. Floral dip: A simplified method for Agrobacterium-mediated transformation of Arabidopsis thaliana. Plant J. 1998, 16, 735–743. [Google Scholar] [CrossRef] [PubMed]
- de Boer, J.M.; Yan, Y.; Smant, G.; Davis, E.L.; Baum, T.J. In situ hybridization to messenger RNA in Heterodera glycines. J. Nematol. 1998, 30, 309–312. [Google Scholar] [PubMed]
- Moter, A.; Gobel, U.B. Fluorescence in situ hybridization (FISH) for direct visualization of microorganisms. J. Microbiol. Methods 2000, 41, 85–112. [Google Scholar] [CrossRef]
- Jacobs, K.A.; Collins-Racie, L.A.; Colbert, M.; Duckett, M.; Golden-Fleet, M.; Kelleher, K.; Kriz, R.; la Vallie, E.R.; Merberg, D.; Spauldin, V.; et al. A genetic selection for isolating cDNAs encoding secreted proteins. Gene 1997, 198, 289–296. [Google Scholar] [CrossRef]
- Oh, S.K.; Young, C.; Lee, M.; Oliva, R.; Bozkurt, T.O.; Cano, L.M.; Win, J.; Bos, J.I.B.; Liu, H.-Y.; van Damme, M.; et al. In planta expression screens of Phytophthora infestans RXLR effectors reveal diverse phenotypes, including activation of the Solanum bulbocastanum disease resistance protein Rpi-blb2. Plant Cell 2009, 21, 2928–2947. [Google Scholar] [CrossRef]
- Trapnell, C.; Roberts, A.; Goff, L.; Pertea, G.; Kim, D.; Kelley, D.R.; Pimentel, H.; Salzberg, S.L.; Rinn, J.L.; Pachter, L. Differential gene and transcript expression analysis of RNA-Seq experiments with TopHat and cufflinks. Nat. Protoc. 2012, 7, 562–578. [Google Scholar] [CrossRef]
- Anders, S.; Reyes, A.; Huber, W. Detecting differential usage of exons from RNA-seq data. Genome Res. 2012, 22, 2008–2017. [Google Scholar] [CrossRef]
- Mi, H.; Muruganujan, A.; Ebert, D.; Huang, X.; Thomas, P.D. PANTHER version 14: More genomes, a new PANTHER GO-slim and improvements in enrichment analysis tools. Nucleic Acids Res. 2019, 47, D419–D426. [Google Scholar] [CrossRef] [PubMed]

Publisher’s Note: MDPI stays neutral with regard to jurisdictional claims in published maps and institutional affiliations. |
© 2022 by the authors. Licensee MDPI, Basel, Switzerland. This article is an open access article distributed under the terms and conditions of the Creative Commons Attribution (CC BY) license (https://creativecommons.org/licenses/by/4.0/).
Share and Cite
Zhang, X.; Lin, R.; Ling, J.; Wang, Y.; Qin, F.; Lu, J.; Sun, X.; Zou, M.; Qi, J.; Xie, B.; et al. Roles of Species-Specific Legumains in Pathogenicity of the Pinewood Nematode Bursaphelenchus xylophilus. Int. J. Mol. Sci. 2022, 23, 10437. https://doi.org/10.3390/ijms231810437
Zhang X, Lin R, Ling J, Wang Y, Qin F, Lu J, Sun X, Zou M, Qi J, Xie B, et al. Roles of Species-Specific Legumains in Pathogenicity of the Pinewood Nematode Bursaphelenchus xylophilus. International Journal of Molecular Sciences. 2022; 23(18):10437. https://doi.org/10.3390/ijms231810437
Chicago/Turabian StyleZhang, Xi, Runmao Lin, Jian Ling, Yunsheng Wang, Feifei Qin, Junru Lu, Xin Sun, Manling Zou, Jing Qi, Bingyan Xie, and et al. 2022. "Roles of Species-Specific Legumains in Pathogenicity of the Pinewood Nematode Bursaphelenchus xylophilus" International Journal of Molecular Sciences 23, no. 18: 10437. https://doi.org/10.3390/ijms231810437
APA StyleZhang, X., Lin, R., Ling, J., Wang, Y., Qin, F., Lu, J., Sun, X., Zou, M., Qi, J., Xie, B., & Cheng, X. (2022). Roles of Species-Specific Legumains in Pathogenicity of the Pinewood Nematode Bursaphelenchus xylophilus. International Journal of Molecular Sciences, 23(18), 10437. https://doi.org/10.3390/ijms231810437

